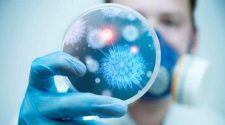
المصدر أونلاين يحاور منظمة الصحة العالمية.. هل بالفعل اليمن خالية من أي إصابة بفيروس كورونا؟ المصدر أونلاين يحاور منظمة الصحة العالمية.. هل بالفعل اليمن خالية من أي إصابة بفيروس كورونا؟

مشاهدة المصدر أونلاين يحاور منظمة الصحة العالمية هل بالفعل اليمن خالية من أي إصابة
يذكر بـأن الموضوع التابع لـ المصدر أونلاين يحاور منظمة الصحة العالمية هل بالفعل اليمن خالية من أي إصابة بفيروس كورونا قد تم نشرة اليوم ( ) ومتواجد على المصدر اونلاين ( اليمن ) وقد قام فريق التحرير في برس بي بالتاكد منه وربما تم التعديل علية وربما قد يكون تم نقله بالكامل اوالاقتباس منه ويمكنك قراءة ومتابعة مستجدادت هذا الخبر او الموضوع من مصدره الاساسي.
وختاما نتمنى ان نكون قد قدمنا لكم من موقع Pressbee تفاصيل ومعلومات، "المصدر أونلاين" يحاور منظمة الصحة العالمية.. هل بالفعل اليمن خالية من أي إصابة بفيروس كورونا؟.
آخر تحديث :
في الموقع ايضا :
- نائب الرئيس الأميركي لـ Fox News: نود أن يتولى السلطة في إيران شخص مستعد للعمل معنا
- With the participation of warplanes… Three new American bases in the Gulf destroyed within hours
- فروق قياسية في أسعار الذهب بين عدن وصنعاء